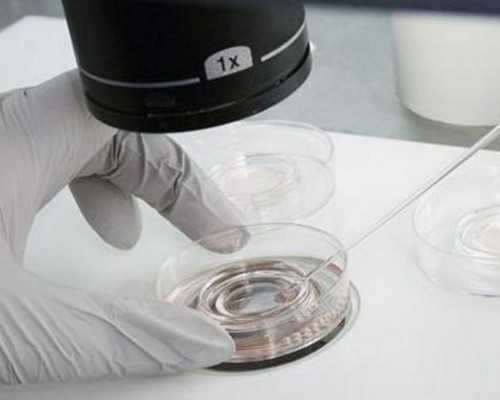
代生双胞胎抱儿子,一、二、三代试管婴儿的优缺点，不孕不育的夫妻应该选择

(苏州找人代生)
从1978年世界上第一位试管婴儿在英国的出生到现在40来年的时间里已经增涨至500多万占据了世界总人口的百分之0.1,国内数据也在不断地增加可见其发展极为迅速。那么是什么原因造成它的发展如此迅速呢?
试管婴儿,一项治疗不孕不育的辅助生殖技术,通过体外授精、体外授精、培育胚胎-胚胎移植等方式治疗一些因身体或其他方面无法自然受孕的人群,受到大多数不孕不育患者的高度关注。随着科技的不断发展试管婴儿技术也比较成熟,在近些年也从当初的第一代技术提升到第二代至今最多选择的第三代试管婴儿。
那么,一代、二代、三代有什么区别呢?今天来总结一下?
第一代试管婴儿
(体外受精胚胎移植IVF-ET)
第一代试管婴儿(体外受精胚胎移植)
手术过程:将女方卵子与男方洗涤过的精子(实际上是将男性精子与精液分离,并脱去活性差的精子)取出后,放置在培养液中让其自然结合受精并发育成胚胎,然而将胚胎植入女性子宫腔内以实现怀孕。
适用人群:女方输卵管堵塞;排卵异常;子宫内膜异位症;先天性不孕。
优缺点:适用人群广,几乎所有不孕不育患者都可以选择,但自然受精的方式容易受到外界因素干扰,成功率稍低(20-30%左右)。
第二代试管婴儿
(卵胞浆内单精子注射(ICSI))
第二代试管婴儿(卵胞浆内单精子注射)
手术过程:取出精卵子后,将男方的单个精子用显微注射器注入女方卵母细胞浆内,使精子与卵子被动结合受精形成受精卵,并通过进行胚胎移植实现怀孕,代替了自然结合的过程。
适用人群:男性精子异常(少精、弱精、无精、精子畸形等);精卵结合障碍;体外受精失败或受精率极低(小于20%)。
优缺点:相比于第一代的自然结合,这种受精过程是辅助受精,所以受精几率要大一些,成功率也高一些(30~50%之间),但因违背自然受精法则,所以会有很大的遗传风险。
第三代试管婴儿
(胚胎植入前遗传学筛查PGS/诊断PGD)
手术过程:首先根据不孕原因选择第一代和第二代方法完成受精,但不同的是,第三代试管需要在胚胎培养阶段,囊胚期(胚胎培养的第5-6天),取出单个或多个卵裂球,进行NGS筛查,诊断出哪些胚胎是正常,哪些胚胎是染色体异常。最终将正常的胚胎进行移植,从而生育最健康的宝宝。
适用人群:夫妻具有遗传疾病(血友病、白化病等);染色体异常;高龄孕妈;习惯性流产。
优缺点:能在一定程度上预防遗传病,选择优质、健康的胚胎移植,也大大提升了成功率(65-80%左右),理论上实现了优生优育的目的,但这项技术对胚胎的质量要求高,实验室必须将受精后的囊胚精密培育5-6天达到送检PGD筛查要求。目前最新技术是NGS检测23对染色体,由于高龄的卵子精子质量较差从而使精子卵子结合后的胚胎出现染色体异常的概率高,可能会出现无健康胚胎可供移植。
医疗技术的提升,目前试管婴儿技术比较成熟三代试管甚至可以做到精卵培育前的基因筛查以及未来宝宝的性别。这就导致一些患者主观的认为通过三代试管技术怀上的宝宝会更健康聪敏从而做出选择。
XYT育儿资讯网-育儿常识全方位解读,助您开启好孕之旅
一二三代试管区别有哪些?2026年一二三代试管费用明细
试管婴儿肯定不是从试管里长大的孩子,他是一种帮助人们怀孕生子的医学技术。医生通过科学方法,将卵子和精子放到一起,进行受精形成受精卵,并在实验室里将受精卵培养成胚胎,植入妈妈的子宫。
通常来说,试管婴儿技术第一代、第二代、第三代间不存在层层递进关系,没有谁比谁好的对比。他们真正的区别在于适用于不同的情况,针对不同的人群,有着不同的选择。
1一代试管婴儿(体外受精胚胎移植)
精子和卵子取出后,卵子和经过优化处理后的精子在体外共同培养,自由结合后实现受精,最终发育成胚胎的过程。
适用人群:对输卵管阻塞、排卵障碍、子宫内膜异位症、不明因素等导致不孕的患者。
2二代试管婴儿(卵胞浆内单精子注射)
通过卵胞浆内单精子显微注射技术,人工将精子注射入卵胞浆内实现受精,达到助孕目的。
适用人群:严重少弱畸形精子症、附睾或睾丸取精、逆行射精、精卵在自然状态下不结合的患者。
3三代试管婴儿(胚胎植入前遗传学筛查)
指经体外受精发育而来的胚胎在行移植前,取胚胎的遗传物质进行遗传学诊断分析,排除染色体或基因异常胚胎,筛选出健康胚胎植入子宫,防止遗传病传递的方法。
适用人群:反复自然流产、家族遗传病史、有生育过遗传病患儿的患者
2026试管婴儿价格明细表
试管婴儿手术的费用一般包括两大部分,一部分是促排卵药物的费用,范围在3000-20000元不等,并且使用进口药和国产药的费用不同,造成费用差别很大,并且年龄越大,用药量越大,费用也就越高。
手术及实验室操作不同价格不同
另一部分是手术及实验室操作费用,并且这部分操作分为一代、二代、三代试管技术,不同的治疗方法价格不同。
第一代试管婴儿技术费用为30000元-40000元;
第二代试管婴儿费用大概在50000元-70000元左右;
第三代试管婴儿费用在90000元-120000元左右。
影响试管费用的因素
试管婴儿费用受多种因素影响,例如患者的身体情况、年龄、选择的医院、医生的技术、促排方案等,下面来给大家介绍哪些因素会导致费用的增加。
男性精子质量差
如果男性质量不好则需要进行处理,则相对增加费用;提前取精则需要精子冷冻保存费用,也相对增加了试管婴儿费用。
女性卵巢功能较差
女性卵巢功能较差,可能用到的促排卵药物费用,检查费用会相对的增加。
试管婴儿费用受多种因素影响
促排卵的药物选择
进口促排药物也会增加试管婴儿费用,促排卵的药物分为进口药和国产药,不同的药物费用也是不同的,相对来说,进口药要贵许多。
试管技术选择
做试管婴儿需要在体外培养胚胎,这就涉及到实验室的培育费,这个费用因不同的治疗方法而不同。
医院选择选择
非专业试管婴儿医院或者小医院,巧立名目收费也会相对增加试管婴儿费用。
各位希望通过试管婴儿技术孕育自己的宝宝的爸爸妈妈,要理性看待这三种技术,它们没有优劣之分,没有二代比一代好,三代比二代好的说法。切勿道听途说,要求医生给做二代或者三代。三种技术都有各自的适应症,请根据自身的检查结果,遵从生殖医学科医生的建议,选择适合的个体化方案。那里能代生孩子>
Tips:
以上就是关于一二三代试管区别有哪些?2026年一二三代试管费用明细的全部内容。如果还有疑惑的话欢迎咨询试管资讯分享平台的专业生殖顾问。祝您好孕~
一二三代试管有什么区别?
回复: '\u3000一代试管婴儿(体外受精—胚胎移植)\n\u3000精子和卵子取出后,卵子和经过优化处理后的精子在体外共同培养,自由结合后实现受精,最终发育成胚胎的过程。\n\u3000适用人群:对输卵管阻塞、排卵障碍、子宫内膜异位症、不明因素等导致不孕的患者。\n\u3000二代试管婴儿(卵胞浆内单精子注射)\n\u3000通过卵胞浆内单精子显微注射技术,人工将精子注射入卵胞浆内实现受精,达到助孕目的。\n\u3000适用人群:严重少弱畸形精子症、附睾或睾丸取精、逆行射精、精卵在自然状态下不结合的患者。\n\u3000三代试管婴儿(胚胎植入前遗传学筛查)\n\u3000指经体外受精发育而来的胚胎在行移植前,取胚胎的遗传物质进行遗传学诊断分析,排除染色体或基因异常胚胎,筛选出健康胚胎植入子宫,防止遗传病传递的方法。\n\u3000使用人群:反复自然流产、家族遗传病史、有生育过遗传病患儿的患者p
[国外试管婴儿可以找人代生吗]